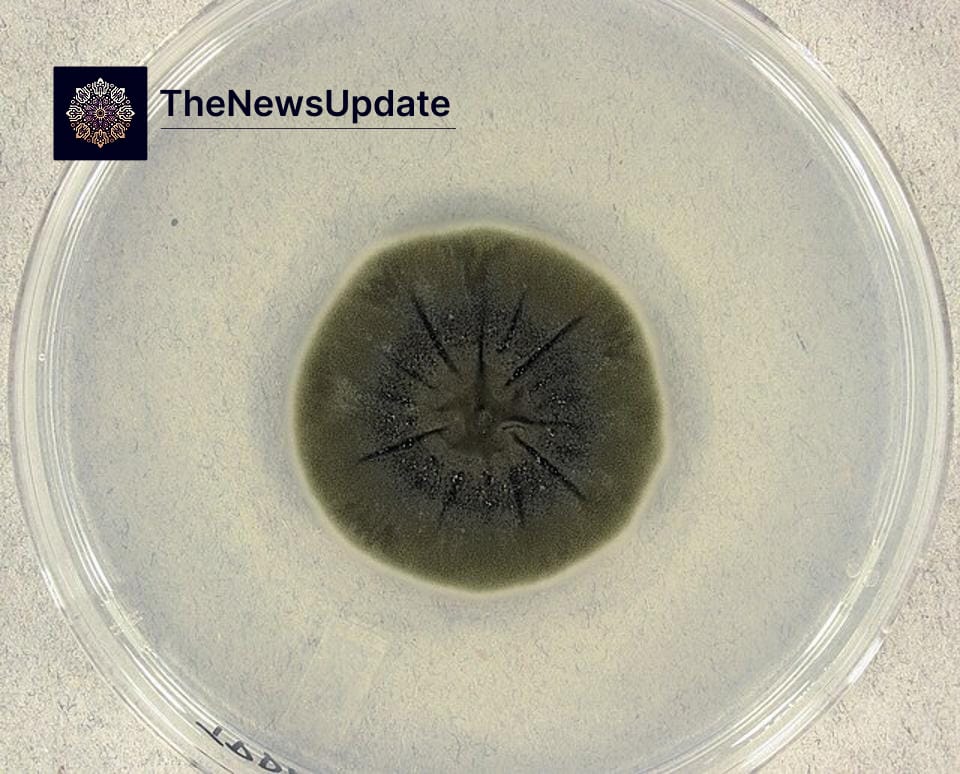
Chernobyl black fungus growing in reactor ruins Chernobyl black fungus: the mould that may eat radiation — science, space plans & caveats — table of contents introduction...

Table of Contents
- Introduction
- Discovery at Chernobyl
- Melanin: Biology’s Radiation Molecule?
- Radiosynthesis — Theory & Evidence
- Lab Work and Space Station Experiments
- Potential Applications: Clean-up & Space Habitats
- Why Some Studies Show No Effect
- Practical Challenges & Safety Concerns
- What Scientists Need to Prove Next
- Conclusion: Promise, Not Proof
Introduction
Chernobyl black fungus — a group of melanised moulds that colonised the ruins of the 1986 reactor — has become one of the more compelling stories at the intersection of microbiology, radiation science and aerospace engineering. Observations from the exclusion zone and later laboratory experiments suggested two surprising facts: these fungi sometimes grow toward sources of ionising radiation, and in some experiments their growth rates actually increased when exposed to radioactivity. That has led researchers to ask two big questions: are these fungi somehow harnessing ionising radiation as an energy source, and could they be used as a biologically derived radiation shield — for nuclear cleanup or even for habitats on the Moon or Mars?
Discovery at Chernobyl
The story begins with field surveys in and around Chernobyl. Researchers exploring the reactor and the surrounding exclusion zone reported dark, melanised fungi on concrete, metal and cable conduits — places with unusually high levels of ionising radiation. Early investigators noticed not just presence but behaviour: fungal hyphae sometimes appeared to grow directionally toward radioactive hotspots, a phenomenon dubbed “radiotropism.”
These field observations were remarkable because ionising radiation is typically destructive to living tissue. Yet the fungal species found inside reactor areas—several different taxa, including Cladosporium sphaerospermum—displayed robust melanisation (black pigmentation) and persistence in environments where many organisms could not survive.
Melanin: Biology’s Radiation Molecule?
At the centre of the story is melanin, a pigment found across life — from human skin to microbes. Melanin is not merely cosmetic. It has chemical properties that allow it to absorb a broad spectrum of electromagnetic energy and act as an antioxidant, neutralising reactive ions that radiation produces.
Researchers hypothesise that melanised fungi might use melanin in two ways: as a shield that absorbs and dissipates ionising energy (reducing cellular damage), and potentially as a transducer that converts part of that energy into biochemical forms usable by the organism. The latter idea is more speculative and under active investigation Chernobyl black fungus.
Radiosynthesis — Theory & Evidence
“Radiosynthesis” is the term some scientists use to describe the hypothesised conversion of ionising-radiation energy into metabolic energy, analogous to how plants convert sunlight through photosynthesis. Key lines of evidence include:

- Field reports of directional growth (radiotropism) toward radiation sources at Chernobyl.
- Laboratory studies showing that some melanised fungi grew faster in the presence of radioactive isotopes than in control conditions.
- Biochemical work suggesting melanin could alter the local redox environment and help process radiation-induced reactive species.
Notable experiments showed modest increases in growth rates for irradiated melanised fungi versus non-irradiated controls, and changes in metabolic markers consistent with stress-response modulation. These results are tantalising but not yet conclusive proof of energy capture in a way comparable to photosynthesis Chernobyl black fungus.
Lab Work and Space Station Experiments
Researchers have taken these fungi out of Chernobyl and into controlled settings — including experiments on the International Space Station. In microgravity and the higher cosmic-radiation environment of low Earth orbit, certain isolates of Cladosporium sphaerospermum exhibited faster growth and provided measurable attenuation of radiation in small-scale sensor tests. A thin biomass layer placed over a sensor in one study reduced the detected dose in the measured spectrum — intriguing given the modest thickness of the fungal sample.
However, interpreting such results is complex. Space experiments expose samples to several simultaneous variables — microgravity, altered atmosphere, and a different radiation mix (galactic cosmic rays rather than terrestrial isotopes). Untangling which factor causes the growth increase remains an active line of inquiry Chernobyl black fungus.
Potential Applications: Clean-up & Space Habitats
If melanised fungi can use radiation or at least protect against it, scientists see two bold application areas:
- Bioremediation of radioactive sites: Fungi could be used to stabilise or sequester radionuclides, slow the spread of contamination, or form part of a biological cleanup toolkit that complements mechanical removal and vitrification.
- Biological radiation shielding for space: “Myco-architecture” — growing fungal walls or biomaterials in situ on the Moon or Mars — could reduce the need to launch heavy shielding. A self-healing, growing barrier made from fungal biomass might provide both structural mass and radioprotection while requiring lower launch mass than concrete or metals.
These ideas are attractive: biological materials can self-repair, be produced from local feedstocks, and potentially be combined with regolith to create hybrid shields. In theory, a living shield that repairs microfractures and regrows after damage would be invaluable for long-term off-world habitats.
Why Some Studies Show No Effect
Scientific results so far are mixed. Several carefully controlled experiments have failed to reproduce strong radiosynthesis effects. Reasons for conflicting results include:
- Species specificity — not all melanised fungi show radiotropic behaviour or growth stimulation.
- Differences in radiation type and energy — gamma rays, beta particles, alpha particles and cosmic rays differ dramatically in how they interact with matter.
- Experimental confounds such as temperature changes, moisture differences or microgravity effects in space experiments that can influence growth independently of radiation.
- Difficulty in measuring tiny energy transduction effects against background metabolic noise.
Because of these variables, many researchers urge caution: the phenomenon could be real but limited, or it might reflect secondary stress responses rather than true metabolic harvesting of radiation.
Practical Challenges & Safety Concerns
The leap from observation to application faces many practical hurdles:
- Scale: The shielding effect measured in petri-dish–scale experiments does not directly translate to habitat-scale protection. Orders of magnitude more biomass — and a predictable, controllable architecture — would be required.
- Radiation types: Galactic cosmic rays are extremely penetrating; effective protection often requires mass (water, polyethylene) or layers of different materials. Biological shields may need to be integrated with other materials.
- Containment and ecology: Introducing fungi to new environments (Earth cleanup sites or extraterrestrial habitats) raises containment and ecological-risk questions. Any engineered fungal solution must avoid unintended spread or environmental damage.
- Human health: Some moulds are allergenic or pathogenic; candidate species need to be benign or engineered for safety.
What Scientists Need to Prove Next
To move from curiosity to credible application, researchers need:
- Clear biochemical mechanisms identifying how melanin interacts with ionising radiation at the molecular level, and how that interaction links to cellular metabolism.
- Reproducible experiments that isolate radiation as the causal variable (controlling for microgravity, temperature and other stressors).
- Scaled tests examining how biomass thickness, density and composition relate to measurable dose attenuation across relevant radiation spectra.
- Engineering approaches for growing, shaping and sustaining fungal biomass in realistic environments — whether a contaminated reactor hall or a lunar regolith module.
Conclusion: Promise, Not Proof
The story of the Chernobyl black fungus is one of science at its most exploratory — field discovery leading to bold laboratory tests and speculative engineering dreams. The evidence so far is provocative: melanised fungi can survive intense radiation, may show directional growth, and in some conditions grow faster in the presence of radiation. Small-scale experiments hint at radioprotective potential.
But the leap from petri dish to planetary shield is long. Radiosynthesis remains a hypothesis that needs mechanistic proof and reproducible demonstration. Even if melanin helps fungi tolerate radiation, translating that ability into robust, scalable protection for humans will require careful, multidisciplinary work — biochemistry, materials science, aerospace engineering and rigorous safety studies.
For now, the black moulds of Chernobyl are an evocative reminder that life can adapt in extreme ways. They invite researchers to rethink the boundaries of biology and to explore whether nature’s gritty survivors might one day play a part in cleaning up our past mistakes — and in protecting our future journeys into space.
By The News Update— Published recently
For more updates The News Update .








